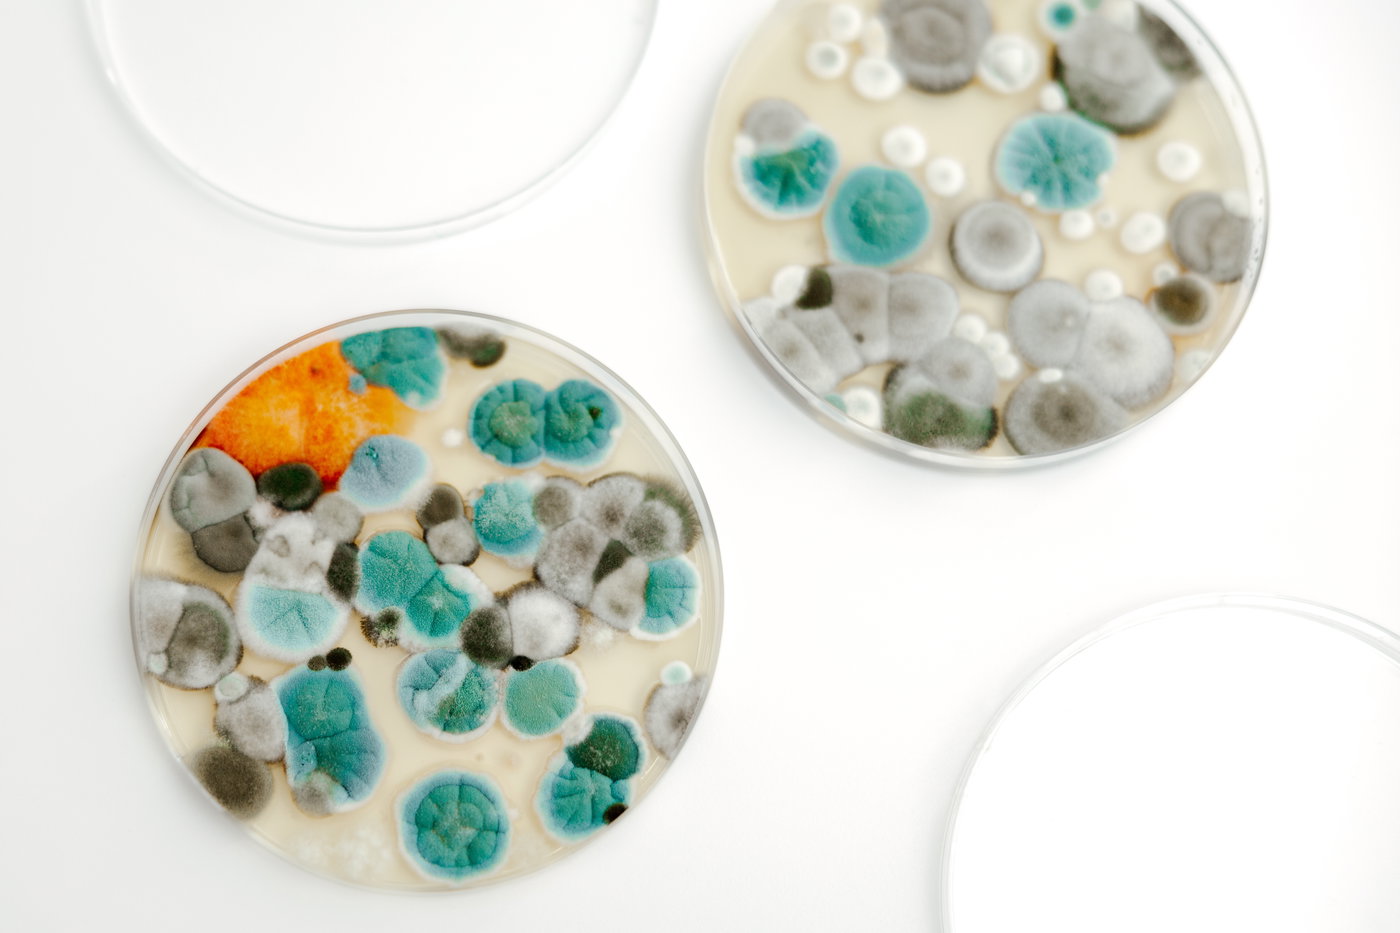
צלחת פטרי ועובש עליה

כולנו שמענו סיפורים שונים על המצאות דגולות שמי שגילה אותם, מדען וותיק או חוקר חובב, עשה זאת בלא כוונה. הוא בכלל חשב להשיג מטרה מסויימת והגיע לתוצאה שונה לחלוטין, אך טובה עשרת מונים מכוונתו המקורית.
>> למגזין המלא - לחצו כאן
התגלית שהיא אולי הידועה ביותר היא תגלית הפניצילין. הרופא והמדען הסקוטי אלכסנדר פלמינג גילה את הפניצילין כמעט במקרה בשנת 1928. הוא עבד במעבדה בלונדון על חיידקים, וכשחזר מחופשה הבחין שאחת מצלחות הפטרי שלו זוהמה בעובש. במקום לזרוק אותה, הוא שם לב לתופעה חריגה: סביב העובש החיידקים פשוט נעלמו. העובש התברר כשייך לסוג Penicillium, והחומר שהפריש - פניצילין - הצליח להרוג חיידקים. הגילוי האקראי הזה הפך למהפכה רפואית אדירה, ששינתה את עולם הרפואה והצילה מיליוני חיים.
בדומה לזה, רבים מהמוצרים הביתיים שנראים לנו כיום כבסיסיים ביותר, החלו גם הם את דרכם כתקלות מעבדה משונות או כמוזרויות מדעיות חסרות פשר, ורק בדיעבד הובנו כפריצות דרך טכנולוגיות. תופעה זו של תגליות אגביות - "סרנדיפיטי" (Serendipity) בלע"ז - מדגימה כיצד קורה שמוזרות ראשונית הופכת למוצר צריכה בסיסי.
לטעות ולגלות - ההמצאות שהגיעו כבדרך אגב
אחד המקרים המפורסמים הוא סיפור המצאת הטפלון (Teflon). בשנת 1938, רוי פלנקט, כימאי צעיר בחברת DuPont, ניסה לפתח סוג חדש של חומר קירור הנקרא כלורופלואורופחמנים (CFCs) לטובת תעשיית הקירור שהייתה אז בחיתוליה. פלנקט מילא מכל גז בלחץ בתערובת של גז TFE וחומצה הידרוכלורית, קירר אותו והניח אותו בצד. כאשר פתח את המכל, הוא גילה להפתעתו כי הגז נעלם, ובמקומו נותרו פתיתים לבנים, חלקלקים ומשונים בתחתית המיכל. חומר בלתי מזוהה זה התגלה כעמיד בפני חום קיצוני וכימיקלים. החומר התגלה כשימושי ביותר ועוד לפני שהפך למוצר ביתי לציפוי מחבתות נגד הידבקות כמעט שלושה עשורים מאוחר יותר, הוא שימש בתעשיית הרכב ואפילו שולב בפרויקט מנהטן של צבא ארצות הברית.
בדומה לכך, המצאת תנור המיקרוגל מבוססת על תופעה ביזארית שאובחנה במהלך מלחמת העולם השנייה. בשנת 1945, פרסי ספנסר, מדען ומהנדס אמריקאי מוביל שעבד במעבדות חברת Raytheon, עסק בבדיקת מגנטרון במסגרת פיתוח מכ"ם. במהלך הפסקת עבודה, ספנסר שם לב כי חטיף שוקולד שהיה מונח בכיסו נמס לחלוטין באורח פלא, מבלי שהיה חשוף למקור חום גלוי. בעוד שאחרים הבחינו בתופעות דומות בעבר אך התעלמו מהן, ספנסר החל לערוך סדרת ניסויים משונים (שכללו פיצוץ ביצים והכנת פופקורן) אשר הובילו להולדת תנור המיקרוגל הראשון - מכשיר שהיה בתחילה עצום ממדים ולא מעשי לשימוש ביתי, בטרם מוזער ועבר תהליך של מסחור.
דבר דומה אירע גם עם מכונת הכתיבה החשמלית, שהומצאה ב-1914 על ידי ג'יימס פילד סמאת'רס ככלי תעשייתי, ורק במחצית השנייה של המאה ה-20 חלחלה כמוצר ביתי נפוץ בטרם הפכה למיושנת.
אך כל זה עדיין בגדר ההיגיון. התגליות היו שימושיות וכאילו רק המתינו שיחשפו אותם. אך לעומת זאת ישנו תחום אחר, תמהוני ומוזר יותר, ובו דברים שנראים משוללי כל היגיון וחסרי תועלת, הופכים להיות להיטים שנמכרים למליוני בני אדם, לתופעה הזו אף יש שם - כלכלת מוזרויות.


מסחור ה"לא-כלום" - כלכלת המוזרויות
אחת התופעות המרתקות ביותר השייכת לתופעה זו של כלכלת המוזרויות החלה להתפתח במחצית השנייה של המאה ה-20 והגיעה לשיאה בעידן הדיגיטלי. מדובר ביכולת של יזמים לארוז ולמכור אבסורד. במקרים רבים הערך השימושי של המוצר שואף לאפס או שולי לחלוטין. והצרכן, בפועל, לא רוכש מוצר, הוא רוחש חוויה ביזארית ולוקח חלק בבדיחה קהילתית עליה הוא אף מוכן לשלם טיבין ותקילין.
שיווק אבנים: הולדתה של חיית המחמד האולטימטיבית
ההוכחה המובהקת ביותר ליכולת למסחר את הלא-כלום היא סיפורה של ה-"Pet Rock" (אבן המחמד). המוצר הומצא ב-1975 על ידי מנהל פרסום ויזם בשם גארי דאהל, והחל את דרכו כשיחת חולין צינית בבר. דאהל, שהאזין לחבריו מתלוננים נחרצות על הקושי, המחויבות והלכלוך הכרוכים בגידול חיות מחמד, הציע להם אלטרנטיבה סאטירית: רכישת אבן. לאבן, טען דאהל, יש יתרונות מוחלטים: היא אינה דורשת האכלה, אינה זקוקה לטיולים, אינה חולה לעולם, היא לא תלעס לך את הנעל או תאכל לך את המסמכים החשובים והיא חיה לנצח. מתוך הבנה עמוקה של עולם השיווק, דאהל גייס משקיעים (עמיתיו ג'ורג' קוקלי וג'ון האגרטי) ורכש חלוקי נחל מחופי סן רוזריטה במקסיקו בעלות מזערית של פחות מסנט לאבן.
גאונותו של דאהל לא הייתה במוצר עצמו, אלא ביצירת הנרטיב השיווקי ועיצוב האריזה. האבנים נארזו בקופסאות קרטון שעיצובן דימה כלוב נשיאה של חיות מחמד, כולל חורי אוורור ומצע של קש נסורת. יתרה מזאת, לכל קופסה צורף "מדריך אילוף" הומוריסטי שהסביר לבעלים החדשים כיצד לטפל באבן, ואף כיצד לאלף אותה לבצע פקודות בסיסיות (למשל, ההנחיה כי לאלף את האבן "לעשות את עצמה מתה" היא הפעולה הקלה ביותר להשגה). הקמפיין לווה גם ביצירת סיפור רקע שטען כי האבנים "אולפו" במקסיקו על ידי מאלף חיות מחמד בדיוני בשם פדרו.
המוצר הושק בתערוכת מתנות בסן פרנסיסקו באוגוסט 1975 והפך מיידית להיסטריה צרכנית ולסמל של אסקפיזם תרבותי. התקשורת האמריקאית, כולל מגזין Newsweek ותוכניות לילה מוכרות מאותה תקופה כזו של ג'וני קרסון (The Tonight Show), העניקו למוצר חשיפה אדירה. במחיר של כ-4 דולר ליחידה (מתוכם כ-95 סנט היו רווח נקי של דאהל לאחר ניקוי כל ההוצאות), נמכרו בתוך חודשיים כ-10,000 אבנים מדי יום. עד סוף תקופת החגים של דצמבר 1975, הגיעו המכירות לכ-1.5 מיליון יחידות, והפכו את דאהל למיליונר באופן מיידי. שיגעון אבן המחמד נמשך כשישה חודשים בלבד, ובפברואר 1976 כבר נמכרו האבנים בהנחה ניכרת בעקבות צניחה בביקוש.
ניסיונותיו המאוחרים של דאהל לשחזר את ההצלחה עם מוצרי 'נובלטי' - גאדג'טים וגימיקים - חלופיים, כגון "ערכות רבייה לחול" או "אדמת סין האדומה", נכשלו לחלוטין. כישלונות ההמשך הללו לימדו חוקרים רבים שחקרו את המקרה שאבן המחמד הייתה תופעה נקודתית, שבה שיווק, אריזה, אירוניה צרכנית והקשר תקופתי חברו יחד ליצירת אב-הטיפוס של תעשיית הצעצועים חסרי התכלית ("Useless Products" בלע"ז) וסימנו את תחילתה של תרבות הסחר המודרני במוצרים חסרי תועלת.

ציניות ככלי שיווקי: חותך הבננות Hutzler 571
בעידן האינטרנט, המנגנון של מכירת מוצרים חסרי תועלת עבר שדרוג: בעוד שאבן המחמד שווקה באופן פעיל כמוצר ציני, כיום פלטפורמות הסחר האלקטרוני הופכות, בעזרת ציניות של גולשים, מוצרים טריוויאליים ומיותרים אבל שהתחילו כמוצרים 'רציניים' ללהיטים בינלאומיים. דוגמה לכך היא חותך הבננות Hutzler 571 – אביזר פלסטיק פשוט וצהוב שנועד לפרוס בננה לפרוסות שוות במכה אחת. מכיוון שחיתוך בננה רכה הוא פעולה פשוטה הדורשת שניות בודדות עם כל סכין מצוי, עצם קיומו של המוצר היווה עילה ללעג.
אך למרות זאת, המוצר הפך לוויראלי באופן חסר תקדים כאשר משתמשי אמזון החלו להציף את עמוד המוצר בביקורות סאטיריות. כ-75% מהביקורות על המוצר מתוארות כחסרות היגיון, בהן הלקוחות משבחים את המוצר כ"משנה חיים" ש"הציל את נישואיהם", או מתלוננים באופן קומי על "פגמים" הנדסיים, כגון טענות שהמכשיר "מעוקל שמאלה" בעוד הבננה שלהם "מעוקלת ימינה", או השוואתו לכלי מלחמה או מכשירי עינויים מימי הביניים. כפי שניסח זאת אחד המבקרים במדויק: "המוצר הזה אינו גדול - הביקורות גדולות". וכך, רק מתוך סקרנות להבין במה מדובר, המוצר המיותר הפך ללהיט מכירות היסטרי שעד היום ניתן לראות באתרים שונים.

פתרונות קיצוניים לבעיות פשוטות
בדומה לכך, השאיפה לייעול המרחב הביתי מביאה איתה גל של מוצרים שהם מסובכים בהרבה מהבעיה שאותה הם מתיימרים לפתור.
אחת הפעולות הביתיות המייגעות ביותר היא קיפול כביסה. בניסיון לבטל מטלה זו, הוצגה בשנת 2019 מכונת ה-FoldiMate. מכונה זו מקבלת לתוכה פריטי לבוש ופולטת אותם לאחר קיפול רובוטי מסודר. אולם, גודלה של המכונה, עלותה, והעובדה הפארודית שאינה מסוגלת להתמודד עם קיפול הפריט המייגע ביותר - גרביים - הפכו אותה לדוגמה קלאסית של הבטחה טכנולוגית שאינה עומדת במבחן המציאות הפשוט.

גם במרחב הפנאי הביתי אנו עדים לפתרונות חריגים לאילוצי מקום. דוגמה לכך היא "דלת הפינג-פונג" (The Ping-Pong Door), שהוצגה בשנת 2018 על ידי הממציא טוביאס פרנזל וחברת FINKELDEI הגרמנית. מדובר בדלת פנים ביתית רגילה למראה, אשר בלחיצת כפתור מסתובבת על צירה האופקי והופכת לשולחן פינג-פונג מתפקד. אף שהמוצר מציע חיסכון במקום, עלותו נאמדת בכ-12,000 דולר להתקנה מותאמת אישית, מה שממקם אותו כאביזר סטטוס לעשירון העליון ולא כפתרון למצוקת דיור חמורה ממנה סובלים בני המעמד הנמוך בעיקר.
בתחום ארוחות הבוקר, חברת Vermont Novelty Toaster Corporation השיקה ב-2014 את ה-Selfie Toaster (מצנם הסלפי), מכשיר החורג מייעודו התזונתי ומאפשר למשתמש להזמין פלטות מתכת מותאמות אישית עם תמונת פניו, אשר נצרבות ישירות על גבי צנימים במהלך הקלייה. הכל מתוך רצון ובניסיון להפיג שיעמום קולינרי.




המקרה של מגב התינוק, ה-Baby Mop, מספק גם הוא תצפית מרתקת על גבולות ההמצאה. הרעיון נולד בסוף שנות ה-90 כבדיחה בספר יפני בשם "101 המצאות יפניות חסרות תועלת" מאת קנג'י קוואקמי. הספר הציג איורים סאטיריים לפיהם ניתן לרתום את זחילתם של תינוקות כדי לנקות את רצפות העץ בבתים יפניים צפופים. למרבה הפלא, בשנת 2012 החליטה חברת BetterThanPants.com האמריקאית לייצר את המוצר הלכה למעשה. החברה פיתחה בגד גוף לתינוקות שעליו נתפרו סיבי מיקרופייבר סופגים לאורך הבטן והגפיים.
המוצר, שמחירו נקבע על 25 פאונד, שווק באופן מסחרי מלא מתוך כוונה גלויה להשתמש בהומור כדי לקדם מכירות, תחת ההבטחה ההיתולית שמעתה התינוק "ילמד מוסר עבודה גבוה מגיל מוקדם", "יעזור לממן את אחזקתו", "ישרוף קלוריות" ו"יישן טוב יותר". ההצלחה הייתה מפתיעה; נציגי החברה דיווחו על מכירת כמאה יחידות בחודש הראשון. בעוד שהלקוחות התייחסו למוצר בקלילות (ולעיתים ייעצו 'להרטיב את התינוק כדי לייעל את הניקיון'), התקבלו גם פניות זועמות מצד גורמים שראו בכך ניצול על גבול ההתעללות בילדים. ה-Baby Mop מוכיח גם הוא כי כאשר משהו נראה טוב ומאחוריו רעיון משעשע, שוק הצריכה המערבי יספוג אותו ויהפוך אותו למוצר מוגמר שימכר בכמויות, תוך התעלמות מכל חשיבה הגיונית.

הפרדוקס של הבית החכם
העידן שלנו, עידן ה"בית החכם", הוביל להמצאות שמטרתן לחבר את המרחב כולו לרשת, אך לעיתים קרובות הפתרונות הטכנולוגים נראים כורכבים עוד יותר מהבעיה אותה הם מנסים לפתור.
חברת LifeSpan, למשל, פיתחה את ה-Ampera office bike – שילוב של אופני כושר סטטיים לכיסא משרדי, במטרה להילחם באורח החיים של פקידים ועובדי הייטק שיושבים הרבה על כסא. הרעיון הוא שאדם יפדל במרץ בזמן קריאת דוא"ל או דו"ח עבודה. ואולם, עיצוב המכשיר התגלה כבעייתי בעליל: מושבו הוא כה גבוה עד שאינו נכנס תחת שולחנות כתיבה רגילים (מה שמחייב קניית "שולחן עמידה" נפרד), גם במצבים הנמוכים שלו הוא היה עדיין גבוה מדי למשתמשים בגובה ממוצע ומטה, מה שיצר מוצר שנוי במחלוקת.
ברמת ניטור הסביבה הביתית, מוצרים כמו ה-BLUE bowl מציגים טרנד עיצובי משונה לחלל המטבח. זוהי קערת פירות עתידנית הכוללת מנגנון המקרין אור כחול עז ישירות על הפירות המונחים בה, במעין אשליה של מים או מפל אור, דבר שנועד להעניק לתפוחים ולבננות מראה זוהר וסינתטי שנועד לפתות את העין, ולמעשה הופך מזון טבעי למיצג נאון הדומה לשלט של חנות רחוב.

בידוד חברתי ובריחה מהמציאות
סדרה נרחבת של המצאות ביתיות משקפת מגמה עצובה משהו המאפיינת את החברה הפוסט-מודרנית: מגפת הבדידות והצורך בבריחה מהמציאות. מוצרים אלו נועדו לספק נחמה מלאכותית ולהוות מחסום בין הפרט לעולם.
כך היא שמיכת ה-Snuggie, שהפכה לתופעה תרבותית אדירה ב-2008 בעקבות קמפיין קניות ויראלי, היא אפשרה לאנשים להישאר מכורבלים תוך שמירה על שימוש בידיים, ואיפשרה לאנשים ל"התעצל מבלי להסתרבל".
המצאה קיצונית בהרבה, שמטרתה לנתק את האדם מסביבתו, היא "כרית היען" (The Ostrich Pillow). כרית עצומת ממדים זו עוטפת את ראשו של המשתמש כליל במראה המזכיר גולם מרופד, ומותירה פתח לאף ולפה ופתחים להשחלת הידיים. הכרית גייסה למעלה מ-130,000 דולר בקיקסטארטר ב-2012, והיא משווקת עד היום ככלי המאפשר לאדם "לברוח מהעולם" ולישון במרחבים משותפים, רכבות או משרדים, תוך יצירת מחיצה אבסורדית מבחינה ויזואלית בינו לבין שאר בני האדם.


ישנן גם המצאות המאפשרות לאדם להביע רגש לסביבה מבלי ליצור אינטרציה אמיתית. פיתוח של חברה יפנית בשם Necomimi בשנת 2012 הוליד אוזני חתול רובוטיות הנחבשות על ראש המשתמש. האוזניים קוראות את גלי המוח האלקטרואנצפלוגרפיים (EEG) של האדם ומגיבות פיזית למצב רוחו: מזדקפות כאשר הוא מגלה עניין, נשמטות בעת רוגע, ומרטטות כשהוא ממוקד.
אתם מותשים וכבר קשה לכם בסביבת העבודה? ה"עניבה-בקבוק" (The Flask Tie) משנת 2013 תאפשר לכם התמודדות (עגומה) עם לחץ, על ידי הסתרת מאגר נוזלים פנימי בתוך העניבה, עם פיית קשית הנסתרת בקצה הצר של העניבה, מה שמאפשר צריכה בלתי מורגשת של אלכוהול על ידי בעלי משרות צווארון לבן במהלך יום עבודה.

צעצועי הילדות שהפכו לתרחיש אימה
תעשיית הצעצועים אמורה לייצג עולם ילדותי תמים ובריא. ואולם, כאשר יצרנים מנסים להעמיס אידיאולוגיות נוקשות על ילדים או לאמץ טרנדים אפלים, התוצאה היא מוצרי פנאי טראומטיים או חסרי כל היגיון.
הניסיון המובהק ביותר למסחר באמפתיה וכאב יושם ב-1965 על ידי חברת הסברו. בעוד שחברת מאטל חגגה את הנהנתנות הקפיטליסטית באמצעות בובת הברבי בעלת בגדי הפאר, הווילות ומכוניות היוקרה, הסברו יצרה את "Little Miss No Name" (העלמה הקטנה ללא שם) כדי ללמד בנות חמלה לאלו ששפר גורלן פחות.
הבובה הייתה התגלמות הדיכאון: היא עוצבה עם עיניים חומות עצומות וריקות ממבט, שיער בלונדיני מלוכלך ופרוע, והיא עמדה יחפה לבושה בשק יוטה עלוב עם טלאים. ידה האחת של הבובה הייתה מושטת קדימה בתנוחת קיבוץ נדבות, ועל פניה הודבקה דמעה ענקית. אריזת הקופסה כללה טקסט קורע לב: "אני צריכה מישהו שיאהב אותי... אנא קחי אותי הביתה איתך ונגבי את דמעתי".
אולם, ילדות סירבו לשחק בייצוג כל כך מדכא מרבית הילדים היו אחוזי אימה מפניה, מה שהוביל להפסקת הייצור המיידית. הניסוי הפסיכולוגי של הסברו כשל. כיום, אותה בובה מרתיעה משמשת כפריט מבוקש לאספנים ומוצגת בארכיוני מוזיאון הכישלונות הבינלאומי.


שנות ה-80 וה-90 העצימו את נטייתן של חברות צעצועים לייצר מושגים מופרכים לחלוטין בניסיון לחקות הצלחות מסחריות קיימות. סדרת צעצועים בשם "Army Ants" החליפה את חיילי הצעצוע מפלסטיק המסורתיים בצבאות נמלים המחולקות לפלגים כחולים וכתומים, העיצוב כלל נמלים שניתן היה לערוף את ראשן ולשגרו כאמצעי לחימה ברחבי החדר.
ליין ביזארי נוסף נקרא "Food Fighters" ("אוכל לוחם"), אשר הציג המבורגרים, נקניקיות ומשולשי פיצה הלבושים כלוחמי קומנדו חמושים בכלי נשק צבאיים - בהם קבוצת "קומנדו המטבח" הטובה נלחמה בקבוצת "דוחיי המקרר" הרעה באמצעות השלכת עגבניות פלסטיק זעירות, בטשטוש מוחלט של הקווים בין הזנה טבעית לאלימות.


אותן שנים התקיימה תופעה עמוקה יותר של צעצועים שהשתלטו לחלוטין על שגרת יומם של המשתמשים. הבובה הרובוטית הקריפית פרבי ששוחררה ב-1998 והפכה מיד לאובססיה בקנה מידה גלובלי. הבובה נראתה כמו הכלאה בין ינשוף לחייזר וכללה מנגנוני למידה משונים שהתבטאו בדיבור באישון לילה, עפעוף מתמיד ושילוב קולות מטריד. ההיסטריה הצרכנית הייתה כה גדולה, שמחיר הצעצוע זינק מ-35 דולר ל-100 דולר בשוק השחור, כאשר 40 מיליון יחידות נמכרו בתוך שלוש שנות הייצור, ו-1.8 מיליון בשנת ההשקה בלבד.
טירוף צרכני מעין זה אינו חדש, הוא מזכיר את שיגעון צעצועי ה"יו-יו" המוכרים מבית היוצר של חברת דאנקן (Duncan Yo-Yo) משנת 1929 - המצאה פיליפינית תמימה שהפכה לאובססיה תחרותית בכל רחבי ארה"ב ובעולם כולו בעקבות קמפיין שיווק אגרסיבי של תחרויות רחוב.

משחקי קופסה תמימים או זירת מאבק אידיאולוגית?
משחקי לוח תופסים מקום ייחודי בתרבות, הם מעוצבים כבילוי משפחתי, אך מתחת לפני השטח פעמים רבות שהם רוויים בכוונות מוסריות, כלכליות ופוליטיות.
משחק הלוח המוכר מכולם, מונופול (Monopoly), עשה שימוש בשיטות של העשירים כדי לצחוק על העשירים. המשחק, ששוחרר ב-1935 ונחשב לשני בפופולריות שלו בעולם אחרי שחמט, לא היה המצאתו המקורית של צ'ארלס דארו כפי שהייצרנים, האחים פארקר, טענו. מקורו במשחק "The Landlord’s Game" שפותח על ידי הפעילה החברתית ליזי מאגי בתחילת המאה ה-20 במטרה מפורשת לבקר וללגלג על החמדנות הקפיטליסטית, תוך הדגמת הנזק שיש למונופולים על החברה. דארו גנב למעשה את המכניקה, הפשיט אותה מהערכים החברתיים שלה, ומכר אותה כמשחק שפועל הפוך כשהוא חוגג דריסת מתחרים ועשיית רווחים, בעוד מאגי עצמה קיבלה לבסוף 500 דולר בלבד עבור זכויותיה.
גם משחקי הילדות התמימים נושאים משאות אפלים: "סולמות ונחשים" החל בהודו כמשחק פילוסופי-דתי שבו העלייה היא לעבר הנאורות והגאולה, והנפילה מדמה את העונש בתוך גיהנום של חטאים. המשחק המוכר "הרמז" (Clue) הומצא כהסחת דעת שנועדה לאפשר לאזרחים הבריטים להעביר את זמנם בזמן שהפצצות חיל האוויר הנאצי נפלו עליהם.


מעבר לאירוניה הלא-מכוונת, מפתחים יצרו פעמים רבות משחקי קופסה פרובוקטיביים שיצרו שערוריות חברתיות חסרות תקדים.
ה־"Juden Raus" (יהודים החוצה), שנוצר בגרמניה הנאצית, נחשב לאחת הדוגמאות הקיצוניות ביותר לשימוש במשחק ככלי להחדרת אידיאולוגיה מסיתה, כאשר מטרתו הייתה לאסוף ולגרש דמויות סטריאוטיפיות של יהודים מחוץ לעיר. זהו עיוות עמוק של רעיון המשחק, שהופך אמצעי תמים לכאורה לכלי חינוכי מסוכן בכוונה תחילה.
גם בעשורים מאוחרים יותר הופיעו משחקים שעוררו סערה ציבורית, אם כי בהקשרים שונים. "Ghettopoly" (גטופולי), למשל, היה ניסיון פארודי שנוי במחלוקת בארצות הברית, אשר השתמש בדימויים גזעניים ועברייניים של שכונות מצוקה כדי לייצר הומור בוטה. התוצאה הייתה הפוכה לחלוטין, והמשחק עורר מחאות חריפות, תביעות משפטיות ודרישות להסרתו מהמדפים.
במקרה אחר, "Public Assistance" הציג תפיסה חברתית טעונה במיוחד, כאשר שחקנים תוגמלו על ניצול מערכות הרווחה. המשחק לעג באופן ישיר לנושאים של עוני, קצבאות והבטחת הכנסה, תוך יצירת פערים חדים בין עובדים קשי יום לבין מי שמוצגים כמנצלי המערכת, ובכך העמיק סטריאוטיפים חברתיים רגישים.
גם גבולות הטעם הועמדו למבחן עם "Serial Killer" (רוצח סדרתי), משחק שבו המשתתף נכנס לנעליו של רוצח ומנסה לחמוק מרשויות החוק. הרעיון עצמו עורר ביקורת קשה בשל הרומנטיזציה של אלימות קיצונית והפיכתה למוקד של חוויה משחקית, מה שהוביל לגינויים נרחבים על חוסר הרגישות והמסר הבעייתי.

האבסורד עובד
בסופו של דבר, מה שנראה מוזר או מיותר הוא דווקא חלק מרכזי בתרבות הצריכה. אנשים לא קונים רק מוצר - הם קונים חוויה, בדיחה פנימית ותחושת שייכות. האבסורד, כשהוא פוגש את הקהל הנכון, הופך למוצר מצליח, ולפעמים מצליח מאוד.
>> למגזין המלא - לחצו כאן
במקביל, גם ביקורת לא תמיד עוזרת, לפעמים היא נטמעת בתוך המוצר והופכת למנוע שדוחף את המוצר אל עבר הצלחה מסחרית. ומה שמפתיע עוד יותר - דווקא פרובוקציה, מבוכה או הומור מצליחים יותר מניסיונות חינוכיים רציניים. כזוהי כלכלת המוזרויות, מוזרה.







0 תגובות